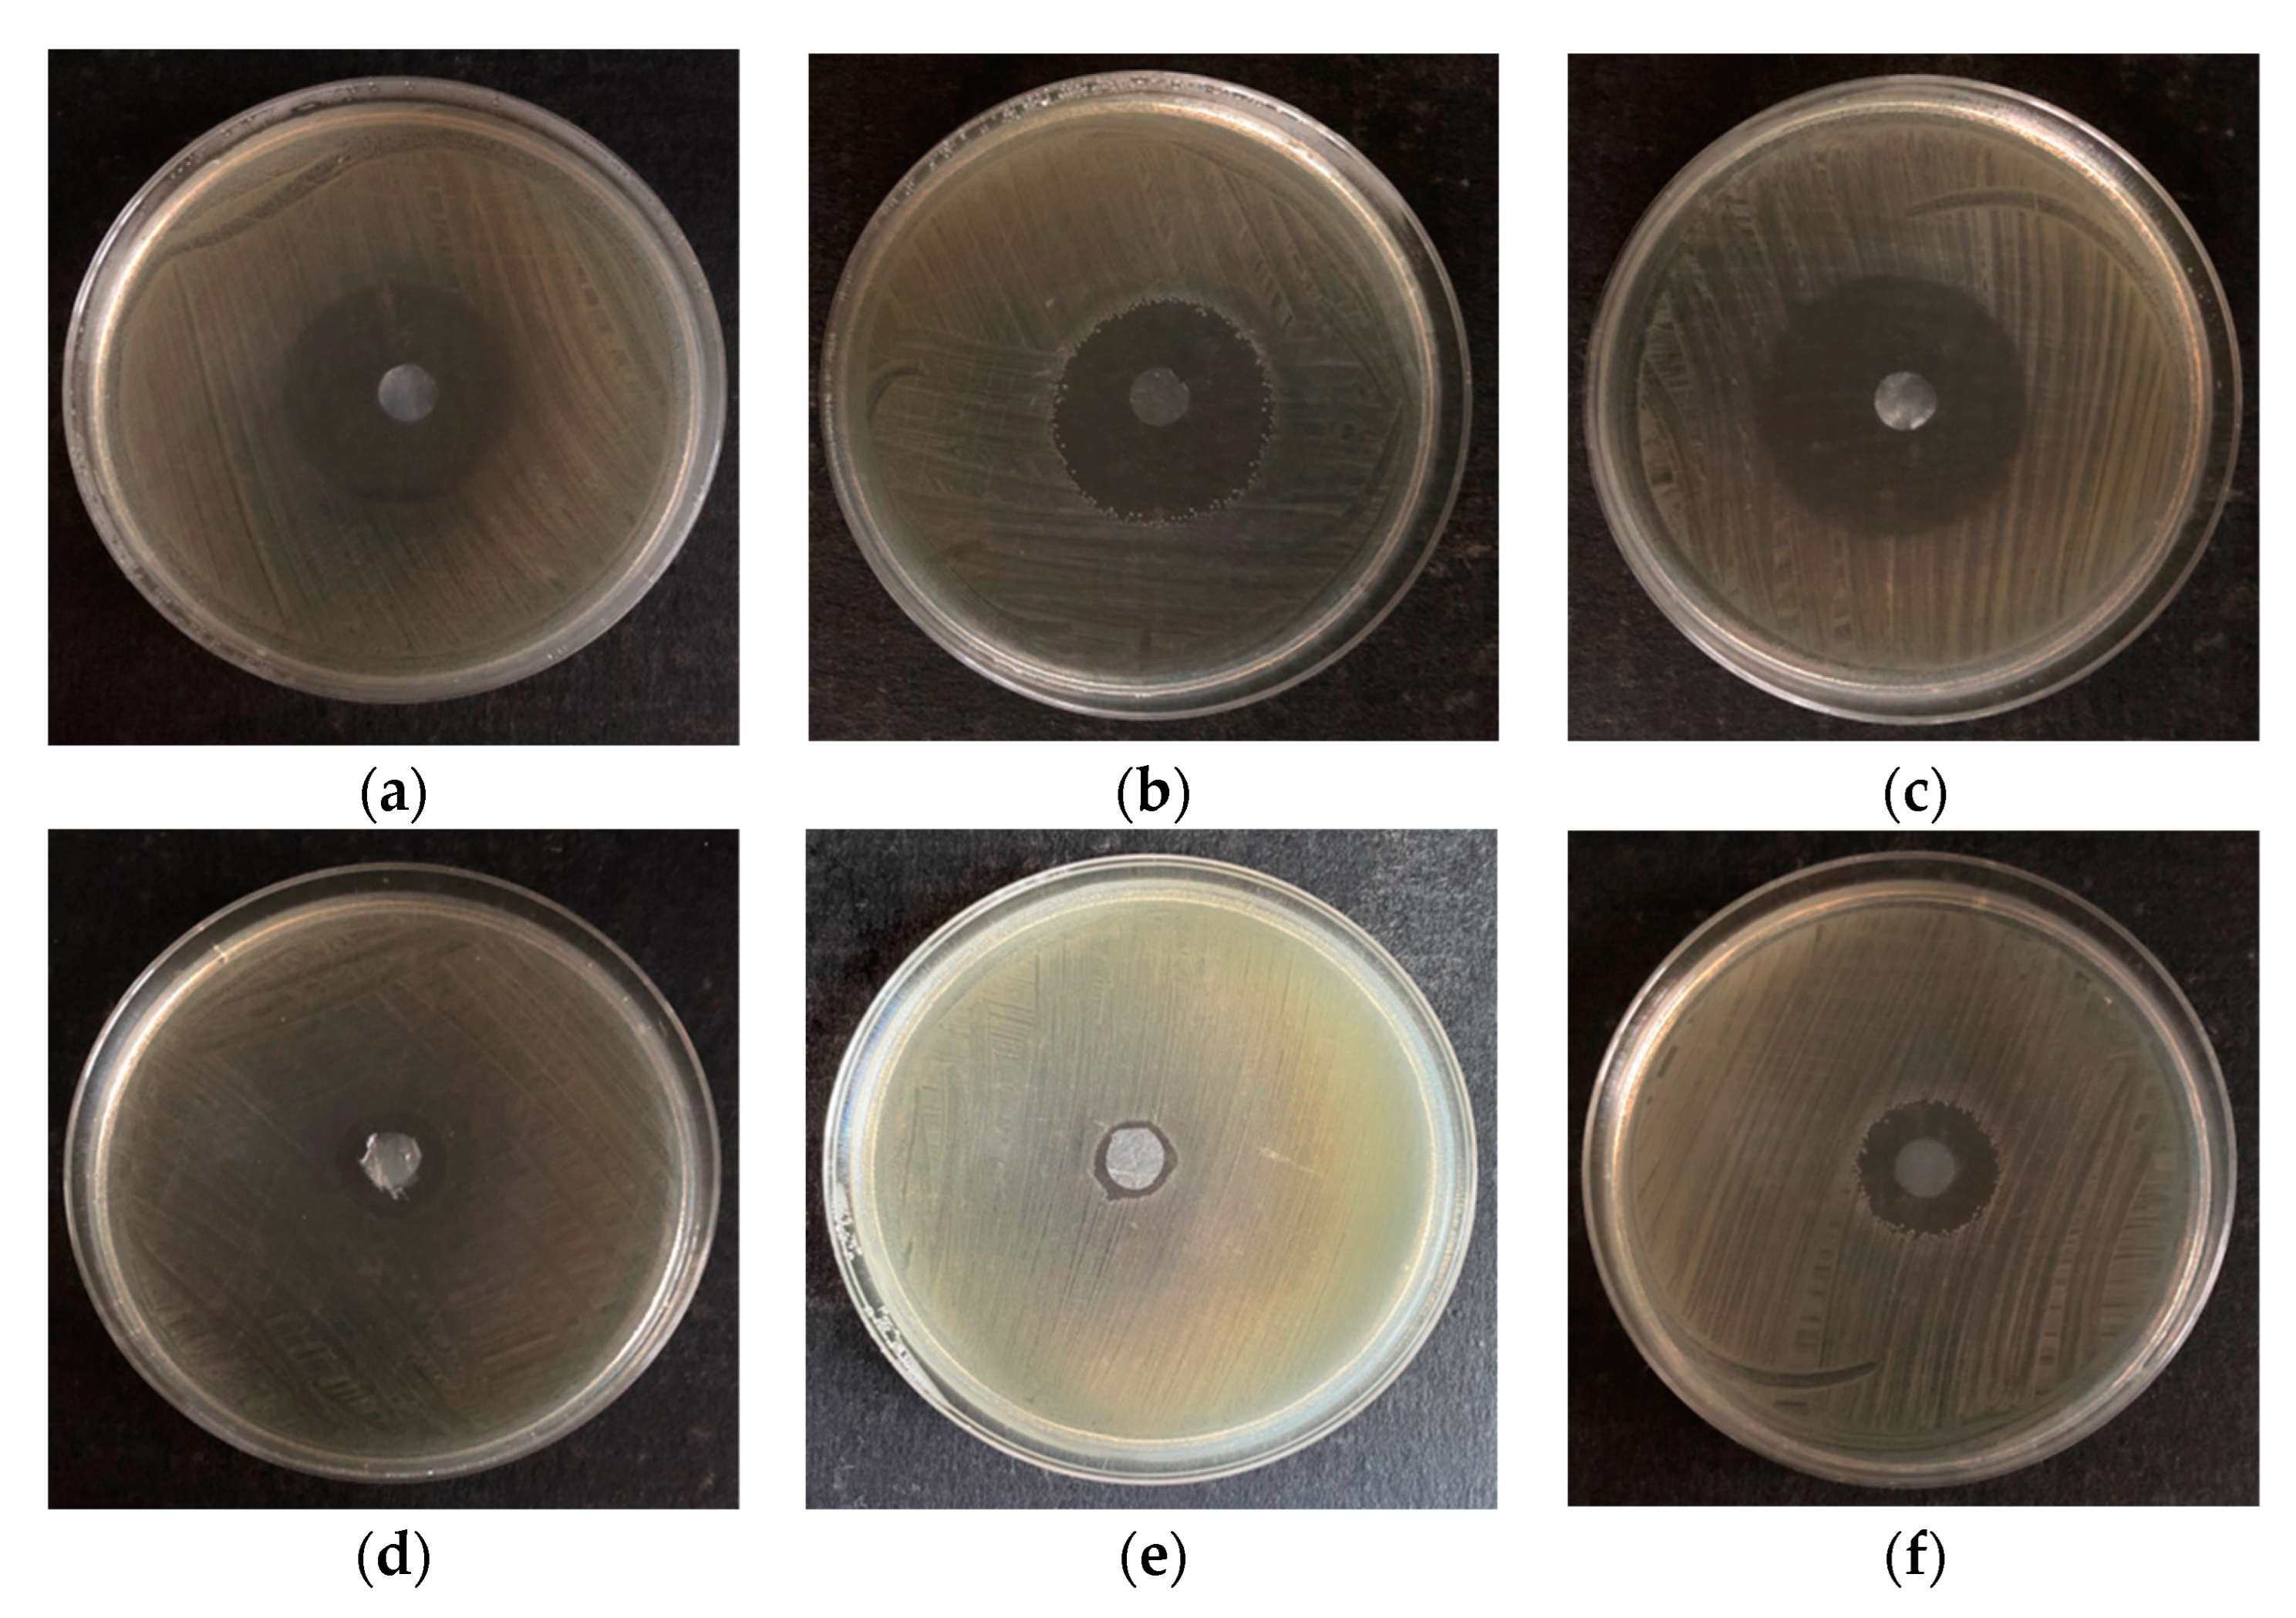
Polymers 16 02316 g003

Antimicrobial Activity against Cronobacter of Plant Extracts and Essential Oils in a Matrix of Bacterial Cellulose
Abstract
1. Introduction
2. Materials and Methods
2.1. Test Strains
2.2. Plant Extracts and Essential Oils
- tulsi (Ocimum sanctum)
- brahmi (Bacopa monnieri)
- lemon (Citrus limon)
- blackberry (Rubus L.)
- nettle root (Urtica dioica L.–radix)
- nettle leaves (Urtica dioica L.–folium) (Applied Biochemistry Sp. z o.o., Poland)
- sage from the sage bush (Salvia shrub) composed of: litronellol, geraniol, limonene, citral, and linalool;
- clove from buds (Eugenia caryophyllus) composed of: eugenol and isoeugenol;
- cinnamon from cinnamon tree bark (Cinnamomum zeylanicum) composed of: cinnamal, linalool, eugenol, d-limonene, benzyl benzoate, coumarin, and cinnamyl alcohol;
- mint from mint leaves (Mentha L.) composed of: l-menthol, menthone, menthyl acetate, limonene, pulegone, and carvone;
- thyme from thyme leaves (Thymus vulgaris) composed of: linalool, limonene, citral, and geraniol;
- lemongrass from East Indian lemongrass (Cymbopogon flexuosus) composed of: citral, geraniol, linalool, limonene, and citronellol;
- rosemary from rosemary leaves/stems (Rosmarinus officinalis) composed of: limonene and linalool;
- lemon from lemon peel (Citrus limonum) composed of: limonene, citral, linalool, citronellol, and geraniol;
- anise from star anise (Illicium verum) composed of: limonene, linalool, and geraniol;
- tea tree (Melaleuca alternifolia) composed of: limonene, linalool, and geraniol;
- lime (Citrus aurantifolia) composed of: limonene, citral, geraniol, linalool, and citronellol;
- grapefruit (Citrus paradisi) composed of: limonene, citral, linalool, geraniol, eugenol, benzyl benzoate, and citronellol;
- tangerine (Citrus reticulata Blanco) composed of: limonene and linalool.
2.3. Preparation of Discs from Bacterial Cellulose
2.4. Microbiological Media
2.5. Determination of Water Activity in Dry Bacterial Cellulose
2.6. Determination of the Absorption Capacity of Essential Oils by Bacterial Cellulose
2.7. Disc Diffusion Method
2.8. Statistical Analysis
3. Results and Discussion
3.1. Water Activity of Bacterial Cellulose
3.2. Antimicrobial Activity of Bacterial Cellulose Impregnated with Plant Extracts against Cronbacter Strains
3.3. Antimicrobial Activity of Essential Oils on the Matrix with BC against Cronobacter
3.4. Assessment of the Absorption Capacity of Extracts and Essential Oils by Bacterial Cellulose
4. Summary
Author Contributions
Funding
Institutional Review Board Statement
Data Availability Statement
Conflicts of Interest
References
- Lustri, W.R.; Barud, H.G.d.O.; Barud, H.d.S.; Peres, M.F.S.; Gutierrez, J.; Tercjak, A.; de Oliveira, O.B.; Ribeiro, S.J.L. Microbial cellulose—Biosynthesis mechanisms and medical applications. In Cellulose—Fundamental Aspects and Current Trends; Poletto, M., Junior, H.L.O., Eds.; InTech: London, UK, 2015; pp. 133–157. [Google Scholar]
- Gorgieva, S.; Trček, J. Bacterial cellulose: Production, modification and perspectives in biomedical applications. Nanomaterials 2019, 9, 1352. [Google Scholar] [CrossRef] [PubMed]
- Ludwicka, K.; Kaczmarek, M.; Białkowska, A. Bacterial nanocellulose—A biobased polymer for active and intelligent food packaging applications: Recent advances and developments. Polymers 2020, 12, 2209. [Google Scholar] [CrossRef] [PubMed]
- Lee, K.Y.; Buldum, G.; Mantalaris, A.; Bismarck, A. More than meets the eye in bacterial cellulose: Biosynthesis, bioprocessing, and applications in advanced fiber composites. Macromol. Biosci. 2014, 14, 10–32. [Google Scholar] [CrossRef] [PubMed]
- Shi, Z.; Zhang, Y.; Phillips, G.O.; Yang, G. Utilization of bacterial cellulose in food. Food Hydrocoll. 2014, 35, 539–545. [Google Scholar] [CrossRef]
- Mesgari, M.; Matin, M.M.; Goharshadi, E.K.; Mashreghi, M. Biogenesis of bacterial cellulose/xanthan/CeO2NPs composite films for active food packaging. Int. J. Biolog. Macromolec. 2024, 133091. [Google Scholar] [CrossRef] [PubMed]
- Papadaki, A.; Lappa, I.K.; Manikas, A.C.; Carbone, M.G.P.; Natsia, A.; Kachrimanidou, V.; Kopsahelis, N. Grafting bacterial cellulose nanowhiskers into whey protein/essential oil film composites: Effect on structure, essential oil release and antibacterial properties of films. Food Hydrocoll. 2024, 147 Part A, 109374. [Google Scholar] [CrossRef]
- Eslahi, H.; Fahimi, N.; Sardarian, A.R. Chemical composition of essential oils. In Essential Oils in Food Processing: Chemistry, Safety and Applications; Hashemi, S.M.b., Khaneghah, A.M., Sant’Ana, A.d.S., Eds.; Wiley: Hoboken, NJ, USA, 2017; pp. 119–171. [Google Scholar]
- Kalemba, D.; Matla, M.; Smętek, A. Antimicrobial activities of essential oils. In Dietary Phytochemicals and Microbes; Patra, A.K., Ed.; Springer: Dordrecht, The Netherlands, 2012; pp. 157–183. [Google Scholar]
- Duarte, M.C.T.; Duarte, R.M.T.; Rodrigues, R.A.F.; Rodrigues, M.V.N. Essential oils and their characteristics. In Essential Oils in Food Processing: Chemistry, Safety and Applications; Hashemi, S.M.b., Khaneghah, A.M., Sant’Ana, A.d.S., Eds.; Wiley: Hoboken, NJ, USA, 2017; pp. 1–19. [Google Scholar]
- Burt, S. Essential oils: Their antibacterial properties and potential applications in foods – a review. Int. J Food Microbiol. 2004, 94, 239. [Google Scholar] [CrossRef] [PubMed]
- Reichling, J.; Schnitzler, P.; Suschke, U.; Saller, R. Essential oils of aromatic plants with antibacterial, antifungal, antiviral, and cytotoxic properties—An overview. Forsch. Komplementärmedizin 2009, 16, 79–90. [Google Scholar] [CrossRef] [PubMed]
- Iversen, C.; Lehner, A.; Mullane, N.; Bidlas, E.; Cleenwerck, I.; Marugg, J.; Fanning, S.; Stephan, R.; Joosten, H. The taxonomy of Enterobacter sakazakii: Proposal of a new genus Cronobacter gen. nov. and descriptions of Cronobacter sakazakii comb. nov. Cronobacter sakazakii subsp. sakazakii, comb. nov., Cronobacter sakazakii subsp. malonaticus subsp. nov., Cronobacter turicensis sp. nov., Cronobacter muytjensii sp. nov., Cronobacter dublinensis sp. nov. and Cronobacter genomospecies 1. BMC Evol. Biol. 2007, 7, 64. [Google Scholar]
- Gemba, M.; Rosiak, E.; Kołożyn-Krajewska, D. Cronobacter spp.–the serious risk in a baby food. Adv. Microbiol. 2020, 59, 140–141. [Google Scholar] [CrossRef]
- Forsythe, S. Cronobacter species. Culture 2010, 21, 1–4. [Google Scholar]
- Sosnowski, M.; Czubkowska, A.; Korpysa-Dzirba, W.; Ostrowska, M.; Roa, J.G.; Osek, J. Cronobacter sakazakii–characteristics and significance in food microbiology. Vet. Med. 2014, 70, 669–672. [Google Scholar]
- Vilela, C.; Kurek, M.; Hayouka, Z.; Röcker, B.; Yildirim, S.; Antunes, M.D.C.; Nilsen-Nygaard, J.; Pettersen, M.K.; Freire, C.S.R. A concise guide to active agents for active food packaging. Trends Food Sci. Technol. 2018, 80, 212–222. [Google Scholar] [CrossRef]
- Silveira, M.F.A.; Soares, N.F.F.; Geraldine, R.M.; Andrade, N.J.; Botrel, D.A.; Gonçalves, M.P.J. Active film incorporated with sorbic acid on pastry dough conservation. Food Control 2007, 18, 1063–1067. [Google Scholar] [CrossRef]
- Guiga, W.; Swesi, Y.; Galland, S.; Peyrol, E.; Degraeve, P.; Sebti, I. Innovative multilayer antimicrobial films made with Nisaplin® or nisin and cellulosic ethers: Physico-chemical characterization, bioactivity and nisin desorption kinetics. Inn. Food Sci. Emerg. Technol. 2010, 11, 352–360. [Google Scholar] [CrossRef]
- Atarés, L.; Chiralt, A. Essential oils as additives in biodegradable films and coatings for active food packaging. Trends Food Sci. Technol. 2016, 48, 51–62. [Google Scholar] [CrossRef]
- Berthold-Pluta, A.; Garbowska, M.; Stefańska, I.; Pluta, A. Microbiological quality of selected ready-to-eat leaf vegetables, sprouts and non-pasteurized fresh fruit-vegetable juices including the presence of Cronobacter spp. Food Microbiol. 2017, 65, 221–230. [Google Scholar] [CrossRef]
- Nagmetova, G.; Berthold-Pluta, A.; Garbowska, M.; Kurmanbayev, A.; Stasiak-Rózańska, L. Antibacterial activity of biocellulose with oregano essential oil against Cronobacter strains. Polymers 2020, 12, 1647. [Google Scholar] [CrossRef] [PubMed]
- Barbosa-Canovas, G.V.; Fontana, A.J., Jr.; Schmidt, S.J.; Labuza, T.P. Water Activity in Foods: Fundamentals and Applications; John Wiley & Sons, Inc.: Hoboken, NJ, USA, 2020. [Google Scholar]
- Zhou, L.; Fu, J.; Bian, L.; Chang, T.; Zhang, C. Preparation of a novel curdlan/bacterial cellulose/cinnamon essential oil blending film for food packaging application, Int. J. Biol. Macromol. 2022, 212, 211–219. [Google Scholar] [CrossRef]
- Moradian, S.; Almasi, H.; Moini, S. Development of bacterial cellulose-based active membranes containing herbal extracts for shelf life extension of button mushrooms (Agaricus bisporus). J. Food Process. Preserv. 2017, 42, e13537. [Google Scholar] [CrossRef]
- Garavito, J.; Moncayo-Martínez, D.; Castellanos, D.A. Evaluation of antimicrobial coatings on preservation and shelf life of fresh chicken breast fillets under cold storage. Foods 2020, 9, 1203. [Google Scholar] [CrossRef] [PubMed]
- Fazlul, M.K.K.; Deepthi, S.P.; Mohammed, I.; Farzana, Y.; Munira, B.; Nazmul, M.H.M. Antibacterial and antifungal activity of various extracts of Bacopa monnieri. Int. J. Pharm. Res. 2019, 11, 1698–1702. [Google Scholar]
- Łojewski, M.; Muszyńska, B.; Sułkowska-Ziaja, K. Bacopa monnieri L. pennell–plant with multitherapeutic activities. Postępy Fitoter. 2014, 2, 84–89. [Google Scholar]
- Kalyani, M.I. A pro-apoptotic 15-kDa protein from Bacopa monnieri activates caspase-3 and downregulates Bcl-2 gene expression in mouse mammary carcinoma cells. J. Nat. Med. 2013, 67, 123–136. [Google Scholar] [CrossRef]
- Sampathkumar, P.; Dheeba, B.; Vidhyasagar, V.; Arulprakash, T.; Vinothkannan, R. Potential antimicrobial activity of various extracts of Bacopa monnieri (Linn.). Int. J. Pharm. 2008, 4, 230–232. [Google Scholar] [CrossRef]
- El Atki, Y.; Aouam, I.; El Kamari, F.; Taroq, A.; Nayme, K.; Timinouni, M.; Lyoussi, B.; Abdellaoui, A. Antibacterial activity of cinnamon essential oils and their synergistic potential with antibiotics. J. Adv. Pharm. Technol. Res. 2019, 10, 63–67. [Google Scholar] [CrossRef]
- Berthold-Pluta, A.; Stasiak-Różańska, L.; Pluta, A.; Garbowska, M. Antibacterial activity of plant-derived compounds and essential oils against Cronobacter strains. Eur. Food Res. Technol. 2019, 245, 1137–1147. [Google Scholar] [CrossRef]
- Raeisi, M.; Tajik, H.; Yarahmadi, A.; Sanginabadi, S. Antimicrobial effect of cinnamon essential oil against Escherichia coli and Staphylococcus aureus. Health Scope 2015, 4, e20808. [Google Scholar] [CrossRef]
- Firmino, F.D.; Cavalcante, A.T.T.; Gomes, A.G.; Firmino, S.C.N.; Rosa, D.L.; De Carvalho, G.M.; Catunda, A.E.F., Jr. Antibacterial and antibiofilm activities of Cinnamomum sp. essential oil and cinnamaldehyde: Antimicrobial activities. Sci. World J. 2018, 9, 7405736. [Google Scholar] [CrossRef]
- Kędzia, A. The activity of peppermint oil (Oleum menthae piperiate) to anaerobic bacteria. Postępy Fitoter. 2007, 4, 182–186. [Google Scholar]
- Khalil, R.; Li, G.Z. Antimicrobial activity of essential oil of Salvia officinalis L. collected in Syria. Afr. J Biotechnol. 2011, 10, 8397–8402. [Google Scholar]
- Cui, H.; Zhang, X.; Zhou, H.; Zhao, C.; Lin, L. Antimicrobial activity and mechanisms of Salvia sclarea essential oil. Bot. Stud. 2015, 56, 16. [Google Scholar] [CrossRef] [PubMed]
- Kozics, K.; Bučková, M.; Puškárová, A.; Kalászová, V.; Cabicarová, T.; Pangallo, D. The effect of ten essential oils on several cutaneous drug-resistant microorganisms and their cyto/genotoxic and antioxidant properties. Molecules 2019, 24, 4570. [Google Scholar] [CrossRef]
- Baydaa, H.A.; Hatem, F.S.; Jumaa, W. A Comparative study of the antibacterial activity of clove and rosemary essential oils on multidrug resistant bacteria. UK J. Pharm. Biosci. 2015, 3, 18–22. [Google Scholar] [CrossRef]
- Kovács, K.J.; Felső, P.; Makszin, L.; Pápai, Z.; Horváth, G.; Ábrahám, H.; Palkovics, T.; Böszörményi, A.; Emődy, L.; Schneider, G. Antimicrobial and virulence-modulating effects of clove essential oil on the foodborne pathogen Campylobacter jejuni. Appl. Environ. Microbiol. 2016, 82, 6158–6166. [Google Scholar] [CrossRef] [PubMed]
- Hu, Q.; Zhou, M.; Wei, S. Progress on the antimicrobial activity research of clove oil and eugenol in the food antisepsis field. J. Food Sci. 2018, 83, 1476–1483. [Google Scholar] [CrossRef]
- Kędzia, A.; Dera-Tomaszewska, B.; Ziółkowska-Klinkosz, M.; Kędzia, W.A.; Wojtaszek-Słomińska, A.; Czernecka, B. Activity of Oleum salvia (Spanish sage essential oil) against aerobic bacteria isolated from oral cavity, respiratory and gastrointestinal tract. Postępy Fitoter. 2011, 4, 238–242. [Google Scholar]
- De Sousa Guedes, J.P.; Da Costa Medeiros, J.A.; De Souza, E.; Silva, R.S.; De Sousa, J.M.B.; Da Conceição, M.L.; De Souza, E.L. The Efficacy of Mentha arvensis L. and M. piperita L. essential oils in reducing pathogenic bacteria and maintaining quality characteristics in cashew, guava, mango, and pineapple juices. Int. J. Food Microbiol. 2016, 238, 183–192. [Google Scholar] [CrossRef] [PubMed]
- Thompson, A.; Meah, D.; Ahmed, N. Comparison of the antibacterial activity of essential oils and extracts of medicinal and culinary herbs to investigate potential new treatments for irritable bowel syndrome. BMC Complement. Altern. Med. 2013, 13, 338. [Google Scholar] [CrossRef]
- Wińska, K.; Mączka, W.; Łyczko, J.; Grabarczyk, M.; Czubaszek, A.; Szumny, A. Essential oils as antimicrobial agents—Myth or real alternative? Molecules 2019, 24, 2130. [Google Scholar] [CrossRef] [PubMed]
- Silveira, S.M.C.; Anildo, S.; Gerson, N.; Secchi, F.L.; Vieira, C.R.W. Chemical composition and antimicrobial activity of essential oils from selected herbs cultivated in the South of Brazil against food spoilage and foodborne pathogens. Ciência Rural 2012, 42, 1300–1306. [Google Scholar] [CrossRef]
- Junka, A.; Żywicka, A.; Chodaczek, G.; Dziadas, M.; Czajkowska, J.; Duda-Madej, A.; Bartoszewicz, M.; Mikołajewicz, K.; Krasowski, G.; Szymczyk, P.; et al. Potential of biocellulose carrier impregnated with essential oils to fight against biofilms formed on hydroxyapatite. Sci. Rep. 2019, 9, 1256. [Google Scholar] [CrossRef] [PubMed]
- Adukwu, E.C.; Bowles, M.; Edwards-Jones, V.; Bone, H. Antimicrobial activity, cytotoxicity and chemical analysis of lemongrass essential oil (Cymbopogon flexuosus) and pure citral. Appl. Microbiol. Biotechnol. 2016, 100, 9619–9627. [Google Scholar] [CrossRef]
- Chao, S.C.; Young, D.G.; Oberg, C.J. Screening for inhibitory activity of essential oils on selected bacteria, fungi and viruses. J. Essent. Oil Res. 2000, 12, 639–649. [Google Scholar] [CrossRef]
- Isman, M.B.; Wilson, J.A.; Bradbury, R. Insecticidal activities of commercial rosemary oils (Rosmarinus officinalis) against Larvae of Pseudaletia unipuncta and Trichoplusia ni. in relation to their chemical compositions. Pharm. Biol. 2008, 46, 82–87. [Google Scholar] [CrossRef]
- Yasin, M.; Younis, A.; Ramzan, F.; Javed, T.; Shabbir, R.; Noushahi, H.; Skalicky, M.; Ondrisik, P.; Brestic, M.; Hassan, S.; et al. Oil from River Tea Tree (Melaleuca bracteate F. Muell.): Antioxidant and antimicrobial properties. Sustainability 2021, 13, 4827. [Google Scholar] [CrossRef]
- Shi, C.; Zhang, X.; Guo, N. The antimicrobial activities and action-mechanism of tea tree oil against food-borne bacteria in fresh cucumber juice. Microb. Pathog. 2018, 125, 262–271. [Google Scholar] [CrossRef]
- Feyzioglu, G.; Tornuk, F. Development of chitosan nanoparticles loaded with summer savory (Satureja hortensis L.) essential oil antimicrobial and antioxidant delivery applications. Food Sci. Technol. 2016, 70, 104–110. [Google Scholar] [CrossRef]
- Król, S.K.; Skalicka-Woźniak, K.; Kandefer-Szerszeń, M.; Stepulak, A. The biological and pharmacological activity of essential oils in the treatment and prevention of infectious diseases. Adv. Hyg. Exo. Med. 2013, 67, 1000–1007. [Google Scholar] [CrossRef]
- Jiji, S.; Udhayakumar, S.; Rose, C.; Muralidharan, C.; Kadirvelu, K. Thymol enriched bacterial cellulose hydrogel as effective material for third degree burn wound repair. Int. J. Biol. Macromol. 2019, 122, 452–460. [Google Scholar] [CrossRef]
- Aziz, M.; Karboune, S. Natural antimicrobial/antioxidant agents in meat and poultry products as well as fruits and vegetables: A review. Crit. Rev. Food Sci. Nutr. 2018, 58, 486–511. [Google Scholar] [CrossRef] [PubMed]
- Ashjaran, A. Properties and applications of bacterial cellulose as a biological non-woven fabric. Asian J. Chem. 2013, 25, 783–788. [Google Scholar] [CrossRef]
- Pogorelova, N.; Rogachev, E.; Digel, I.; Chernigova, S.; Nardin, D. Bacterial cellulose nanocomposites: Morphology and mechanical properties. Materials 2020, 13, 2849. [Google Scholar] [CrossRef] [PubMed]
- Ul-Islam, M.; Khan, T.; Park, J.K. Water holding and release properties of bacterial cellulose obtained by in situ and ex situ modification. Carbohydr. Polym. 2012, 88, 596–603. [Google Scholar] [CrossRef]

| Bacterial Strain | Inhibition Zone [mm] ± SD Caused by the Presence of a Given Essential Oil | |||||||||||||
|---|---|---|---|---|---|---|---|---|---|---|---|---|---|---|
| Oil | Control | |||||||||||||
| Cinnamon | Sage | Clove | Mint | Thyme | Lemongrass | Rosemary | Lemon | Anisic | Tea Tree | Lime | Grapefruit | Tangerine | ||
| C. muytjensii ATCC 51329 | 34.62 e ± 1.51 | 10.05 b ± 0.81 | 21.50 c ± 1.55 | 15.61 a ± 2.32 | 44.37 c ± 3.30 | 18.81 c ± 1.27 | 11.82 ab ± 0.13 | 0.00 a | 10.32 b ± 0.24 | 8.69 a ± 0.60 | 9.10 a ± 1.14 | 0.00 a | 0.00 a | 0.00 a |
| C. sakazakii ATCC 29544 | 28.46 c ± 1.27 | 9.88 b ± 0.15 | 16.73 b ± 0.31 | 13.04 a ± 1.06 | 21.80 a ± 1.03 | 12.90 ab ± 0.57 | 11.02 ab ± 0.96 | 0.00 a | 0.00 a | 10.18 a ± 0.71 | 9.27 ab ± 1.15 | 0.00 a | 0.00 a | 0.00 a |
| C. sakazakii lv27 | 24.17 b ± 1.02 | 0.00 a | 15.95 ab ± 0.67 | 11.89 a ± 0.88 | 90.53 d ± 1.29 | 13.90 b ± 0.88 | 9.47 a ± 0.08 | 0.00 a | 0.00 a | 11.05 a ± 1.69 | 10.99 ab ± 1.55 | 0.00 a | 0.00 a | 0.00 a |
| C. malonaticus lv31 | 32.10 de ± 0.87 | 0.00 a | 15.94 ab ± 0.56 | 13.91 a ± 2.02 | 30.61 b ± 1.99 | 12.27 ab ± 0.64 | 18.20 c ± 1.01 | 0.00 a | 0.00 a | 9.98 a ± 1.34 | 13.00 b ± 2.00 | 0.00 a | 0.00 a | 0.00 a |
| C. condimenti s37 | 29.05 cd ± 1.78 | 13.21 c ± 2.29 | 19.73 bc ± 1.69 | 14.92 a ± 2.33 | 30.87 b ± 0.28 | 11.52 a ± 0.19 | 14.10 abc ± 3.12 | 10.35 b ± 0.27 | 0.00 a | 11.97 a ± 2.02 | 9.24 ab ± 1.74 | 0.00 a | 0.00 a | 0.00 a |
| C. muytjensii s50 | 24.19 b ± 1.27 | 9.72 b ± 0.55 | 20.40 bc ± 3.40 | 12.31 a ± 1.90 | 29.59 b ± 1.71 | 11.62 a ± 0.21 | 16.72 c ± 2.54 | 0.00 a | 0.00 a | 12.59 a ± 2.53 | 9.11 a ± 1.00 | 0.00 a | 0.00 a | 0.00 a |
| C. turicensis lv53 | 9.51 a ± 0.52 | 11.26 c ± 0.50 | 12.23 a ± 0.58 | 12.89 a ± 1.13 | 17.14 a ± 2.15 | 11.37 a ± 0.09 | 14.19 bc ± 1.25 | 0.00 a | 0.00 a | 19.80 b ± 2.72 | 8.44 a ± 0.51 | 0.00 a | 0.00 a | 0.00 a |
Disclaimer/Publisher’s Note: The statements, opinions and data contained in all publications are solely those of the individual author(s) and contributor(s) and not of MDPI and/or the editor(s). MDPI and/or the editor(s) disclaim responsibility for any injury to people or property resulting from any ideas, methods, instructions or products referred to in the content. |
© 2024 by the authors. Licensee MDPI, Basel, Switzerland. This article is an open access article distributed under the terms and conditions of the Creative Commons Attribution (CC BY) license (https://creativecommons.org/licenses/by/4.0/).
Share and Cite
Stasiak-Różańska, L.; Berthold-Pluta, A.; Aleksandrzak-Piekarczyk, T.; Koryszewska-Bagińska, A.; Garbowska, M. Antimicrobial Activity against Cronobacter of Plant Extracts and Essential Oils in a Matrix of Bacterial Cellulose. Polymers 2024, 16, 2316. https://doi.org/10.3390/polym16162316
Stasiak-Różańska L, Berthold-Pluta A, Aleksandrzak-Piekarczyk T, Koryszewska-Bagińska A, Garbowska M. Antimicrobial Activity against Cronobacter of Plant Extracts and Essential Oils in a Matrix of Bacterial Cellulose. Polymers. 2024; 16(16):2316. https://doi.org/10.3390/polym16162316
Chicago/Turabian StyleStasiak-Różańska, Lidia, Anna Berthold-Pluta, Tamara Aleksandrzak-Piekarczyk, Anna Koryszewska-Bagińska, and Monika Garbowska. 2024. "Antimicrobial Activity against Cronobacter of Plant Extracts and Essential Oils in a Matrix of Bacterial Cellulose" Polymers 16, no. 16: 2316. https://doi.org/10.3390/polym16162316
APA StyleStasiak-Różańska, L., Berthold-Pluta, A., Aleksandrzak-Piekarczyk, T., Koryszewska-Bagińska, A., & Garbowska, M. (2024). Antimicrobial Activity against Cronobacter of Plant Extracts and Essential Oils in a Matrix of Bacterial Cellulose. Polymers, 16(16), 2316. https://doi.org/10.3390/polym16162316






